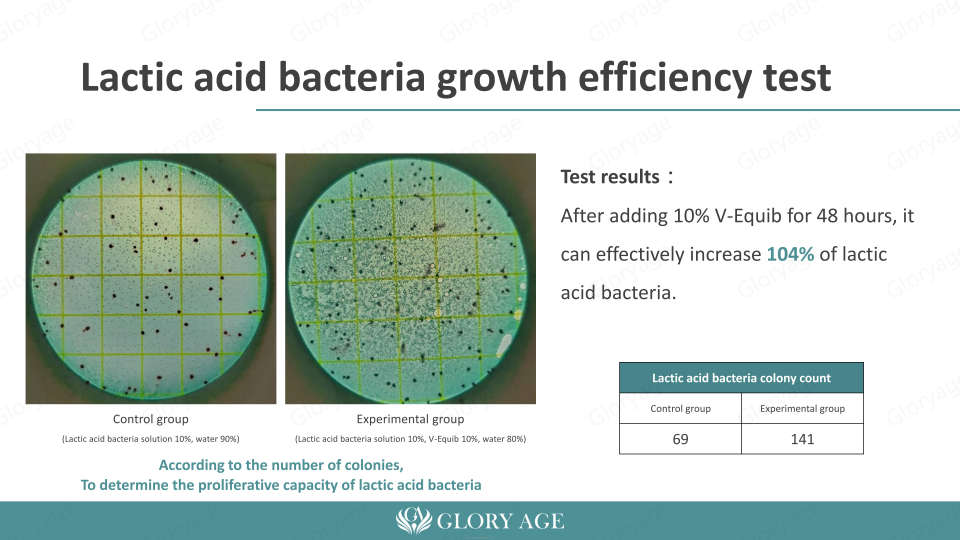

Natural Anti-Bacterial Cosmetic Grade Ingredient for Feminine Wash Vaginal Hygiene Products with pH 3.5-4.5 Non-Drug Solution
No reviews yet

GLORY AGE CO., LTD.4 yrs

Attributes
V-Equibmodel number
Taiwan, Chinaplace of origin
Gloryagebrand name
Cosmetic GradeGrade
3.5~4.5PH Value
Slight OrderODOR
Shelf life:36 months
storage:Keep container unopened in cool, dry place,Keep away from heat & light
Function:Vaginal Care, Vaginal pH Balance
Dosage:1%~10%
INCI:Lactic Acid, Citric Acid, Sodium Lactate, Sodium Citrate, Mannose
Feature:Non-drug, the best Vaginal care solution
Product Applications:-Water soluble -For O/W or W/O emulsions -Vaginal Care Products
Key attributes
model number
V-Equib
place of origin
Taiwan, China
brand name
Gloryage
Grade
Cosmetic Grade
PH Value
3.5~4.5
ODOR
Slight Order
Shelf life
36 months
storage
Keep container unopened in cool, dry place,Keep away from heat & light
Function
Vaginal Care, Vaginal pH Balance
Dosage
1%~10%
INCI
Lactic Acid, Citric Acid, Sodium Lactate, Sodium Citrate, Mannose
Feature
Non-drug, the best Vaginal care solution
Product Applications
-Water soluble -For O/W or W/O emulsions -Vaginal Care Products
Packaging and delivery
Selling Units
Single item
Single package size
13.5X5.5X21 cm
Single gross weight
0.050 kg
Lead time
Customization options
customization MOQ (Min. order: 1 kilogram)
View details
Product descriptions from the supplier
Warning/Disclaimer
California Proposition 65 Consumer WarningView more
FREE shipping capped at $20
1 - 49 kilograms
$29250
>= 50 kilograms
$26325
Sample price: $1
4 interest-free payments with
Alibaba.com order protection
Secure payments
Every payment you make on Alibaba.com is secured with strict SSL encryption and PCI DSS data protection protocols
Money-back protection
Claim a refund if your order doesn't ship, is missing, or arrives with product issues












